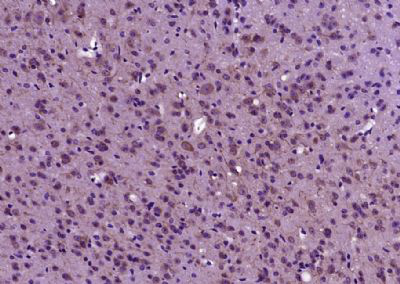

产品货号 : mlR11742
英文名称 : DMPK
中文名称 : 肌强直性营养不良蛋白激酶抗体
别 名 : Dystrophia myotonica protein kinase; DM 1; DM; DM kinase; DM protein kinase; DM-kinase; DM1; DM1 protein kinase; DM1PK; DMK; DMPK; DMPK_HUMAN; Dystrophia myotonica 1; Dystrophia myotonica protein kinase; MDPK; MT PK; MT-PK; Myotonic dystrophy associated protein kinase; Myotonic dystrophy protein kinase; Myotonin protein kinase A; Myotonin protein kinase; Myotonin-protein kinase; Thymopoietin homolog.
研究领域 : 心血管 神经生物学 信号转导 激酶和磷酸酶
抗体来源 : Rabbit
克隆类型 : Polyclonal
交叉反应 : Human, Mouse, Rat, Dog, Pig, Cow, Sheep,
产品应用 : ELISA=1:500-1000 IHC-P=1:400-800 IHC-F=1:400-800 ICC=1:100-500 IF=1:100-500 (石蜡切片需做抗原修复)
not yet tested in other applications.
optimal dilutions/concentrations should be determined by the end user.
分 子 量 : 69kDa
细胞定位 : 细胞核 细胞浆 细胞膜
性 状 : Lyophilized or Liquid
浓 度 : 1mg/ml
免 疫 原 : KLH conjugated synthetic peptide derived from human DMPK:51-120/629
亚 型 : IgG
纯化方法 : affinity purified by Protein A
储 存 液 : 0.01M TBS(pH7.4) with 1% BSA, 0.03% Proclin300 and 50% Glycerol.
保存条件 : Store at -20 °C for one year. Avoid repeated freeze/thaw cycles. The lyophilized antibody is stable at room temperature for at least one month and for greater than a year when kept at -20°C. When reconstituted in sterile pH 7.4 0.01M PBS or diluent of antibody the antibody is stable for at least two weeks at 2-4 °C.
PubMed : PubMed
产品介绍 : Myotonic dystrophy protein kinase is a multi-domain protein kinase found in muscle that is activated in response to G protein second messengers and proteolysis (1). DMPK is implicated in myotonic muscular dystrophy (DM), an autosomal dominant-inherited disorder that predominately affects skeletal and cardiac muscle and causes defects in cardiac conduction (2,3). DM arises through expansion of CTG repeats in the 3’-UTR of the DMPK gene (4). Mutant DMPK transcripts with an extended region of CUG repeats are retained in the nucleus (5). These transcripts also influence the expression of the DM locus-associated homeodomain protein (DMAHP)/SIX5, to mediate in part the DM phenotype (6). Other substrates for DMPK include myogenin, L-type calcium channels, and Phospholemman (PLM) (1).
Function:
Non-receptor serine/threonine protein kinase which isnecessary for the maintenance of skeletal muscle structure andfunction. May play a role in myocyte differentiation and survivalby regulating the integrity of the nuclear envelope and theexpression of muscle-specific genes. May also phosphorylatePPP1R12A and inhibit the myosin phosphatase activity to regulatemyosin phosphorylation. Also critical to the modulation of cardiaccontractility and to the maintenance of proper cardiac conductionactivity probably through the regulation of cellular calciumhomeostasis. Phosphorylates PLN, a regulator of calcium pumps andmay regulate sarcoplasmic reticulum calcium uptake in myocytes. Mayalso phosphorylate FXYD1/PLM which is able to induce chloridecurrents. May also play a role in synaptic plasticity.
Subunit:
Homodimer; homodimerization stimulates the kinaseactivity. Interacts with HSPB2; may enhance DMPK kinase activity.Interacts with PLN; phosphorylates PLN. May interact with RAC1; mayregulate DMPK kinase activity. Interacts with LMNA; may regulatenuclear envelope stability.
Subcellular Location:
Endoplasmic reticulum membrane; Single-passtype IV membrane protein; Cytoplasmic side (By similarity). Nucleusouter membrane; Single-pass type IV membrane protein; Cytoplasmicside (Probable). Mitochondrion outer membrane; Single-pass type IVmembrane protein (Probable). Sarcoplasmic reticulum membrane (Bysimilarity). Cell membrane (By similarity). Cytoplasm, cytosol (Bysimilarity). Note=Localizes to sarcoplasmic reticulum membranes ofcardiomyocytes (By similarity).
Isoform 1: Mitochondrion membrane.
Isoform 3: Mitochondrion membrane.
Tissue Specificity:
Most isoforms are expressed in many tissues including heart, skeletal muscle, liver and brain, except for isoform 2 which is only found in the heart and skeletal muscle, and isoform 14 which is only found in the brain, with high levels in the striatum, cerebellar cortex and pons.
Post-translational modifications:
Phosphorylated. Autophosphorylates. Phosphorylation by RAF1may result in activation of DMPK.
Proteolytic processing of the C-terminus may remove thetransmembrane domain and release the kinase from membranesstimulating its activity.
DISEASE:
Defects in DMPK are the cause of dystrophia myotonica type 1 (DM1) [MIM:160900]; also known as Steinert disease. A muscular disorder characterized by myotonia, muscle wasting in the distal extremities, cataract, hypogonadism, defective endocrine functions, male baldness and cardiac arrhythmias. Note=The causative mutation is a CTG expansion in the 3'-UTR of the DMPK gene. A length exceeding 50 CTG repeats is pathogenic, while normal individuals have 5 to 37 repeats. Intermediate alleles with 35-49 triplets are not disease-causing but show instability in intergenerational transmissions. Disease severity varies with the number of repeats: mildly affected persons have 50 to 150 repeats, patients with classic DM have 100 to 1,000 repeats, and those with congenital onset can have more than 2,000 repeats.
Similarity:
Belongs to the protein kinase superfamily. AGC Ser/Thr protein kinase family. DMPK subfamily.
Contains 1 AGC-kinase C-terminal domain.
Contains 1 protein kinase domain.
SWISS:
Q09013
Gene ID:
1760
Important Note:
This product as supplied is intended for research use only, not for use in human, therapeutic or diagnostic applications.
产品图片